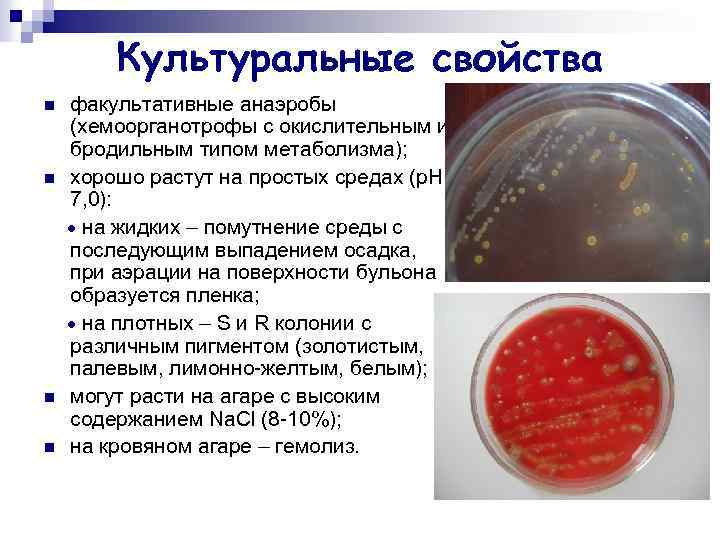
Культуральные свойства n n факультативные анаэробы (хемоорганотрофы с окислительным и бродильным типом метаболизма); хорошо
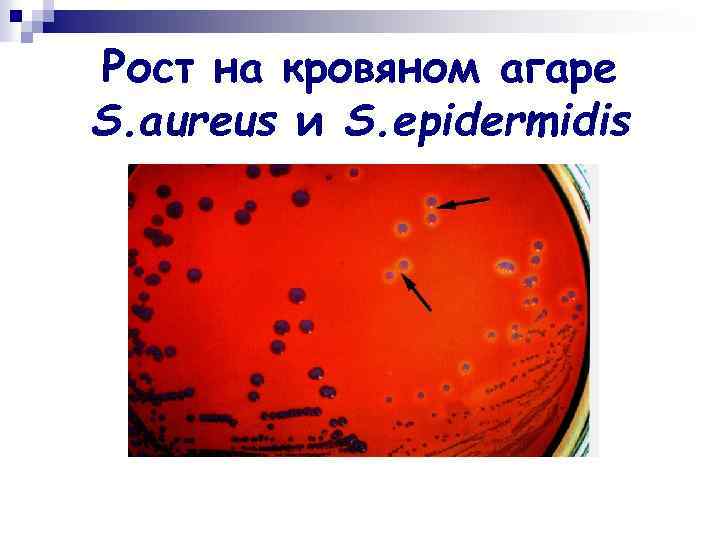
Рост на кровяном агаре S. aureus и S. epidermidis
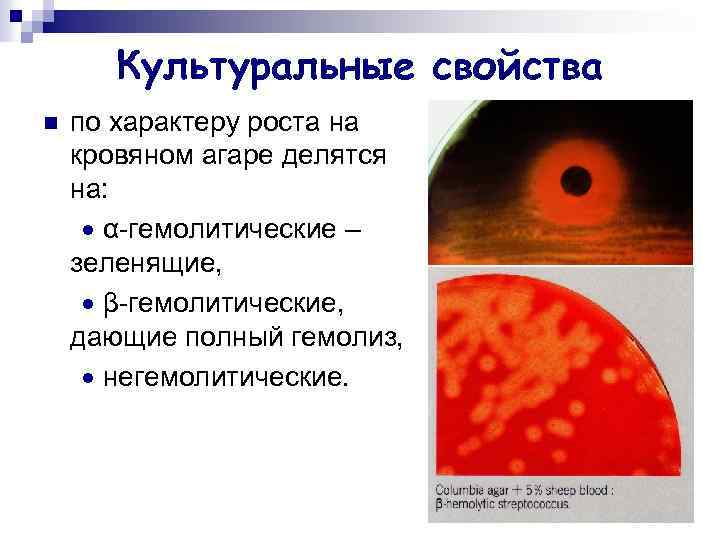
Культуральные свойства n по характеру роста на кровяном агаре делятся на: α-гемолитические – зеленящие,
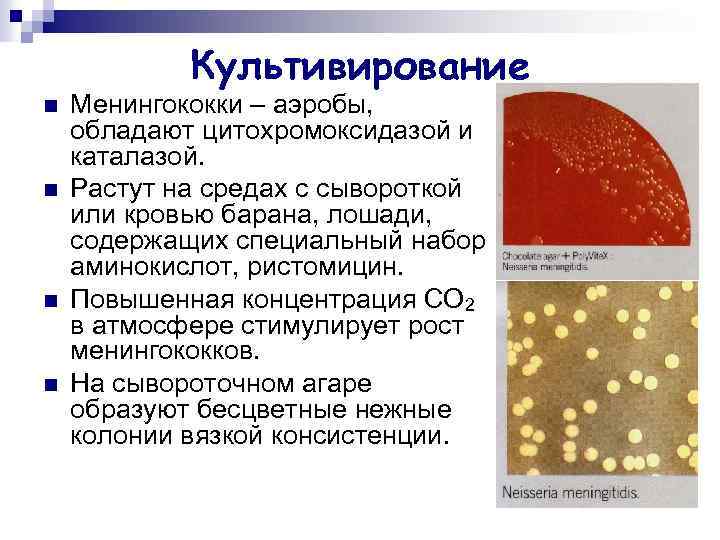
Культивирование n n Менингококки – аэробы, обладают цитохромоксидазой и каталазой. Растут на средах с

05.3. Патогенные Кокки.ppt
- Количество слайдов: 80
 ПАТОГЕННЫЕ КОККИ
ПАТОГЕННЫЕ КОККИ
 ПАТОГЕННЫЕ КОККИ Патогенные и условно-патогенные. n Строгие анаэробы (пептококки, пептострептококки, вейлонеллы), факультативные анаэробы и аэробы (стрептококки, стафилококки, нейссерии). n Гнойно-воспалительные болезни различной локализации и тяжести. n
ПАТОГЕННЫЕ КОККИ Патогенные и условно-патогенные. n Строгие анаэробы (пептококки, пептострептококки, вейлонеллы), факультативные анаэробы и аэробы (стрептококки, стафилококки, нейссерии). n Гнойно-воспалительные болезни различной локализации и тяжести. n
 ОБЩАЯ ХАРАКТЕРИСТИКА ПАТОГЕННЫХ КОККОВ ВОЗБУДИТЕЛЬ СТАФИЛОКОККИ ПАТОГЕННОСТЬ ГРАМ ТОКСИН ЧЕЛОВЕК, ЖИВОТНЫЕ Г+ ЭКЗО ЧЕЛОВЕК Г– ЭНДО СТРЕПТОКОККИ МЕНИНГОКОККИ ГОНОКОККИ РАСПРОСТРАНЕННОСТЬ ФЕРМЕНТЫ РЕЗИСТЕНТНОСТЬ ТРЕБОВАТЕЛЬНОСТЬ К ПИТАТЕЛЬНЫМ СРЕДАМ
ОБЩАЯ ХАРАКТЕРИСТИКА ПАТОГЕННЫХ КОККОВ ВОЗБУДИТЕЛЬ СТАФИЛОКОККИ ПАТОГЕННОСТЬ ГРАМ ТОКСИН ЧЕЛОВЕК, ЖИВОТНЫЕ Г+ ЭКЗО ЧЕЛОВЕК Г– ЭНДО СТРЕПТОКОККИ МЕНИНГОКОККИ ГОНОКОККИ РАСПРОСТРАНЕННОСТЬ ФЕРМЕНТЫ РЕЗИСТЕНТНОСТЬ ТРЕБОВАТЕЛЬНОСТЬ К ПИТАТЕЛЬНЫМ СРЕДАМ
 Патогенные кокки Грамположительные Грамотрицательные
Патогенные кокки Грамположительные Грамотрицательные
 Грамположительные кокки n Стафилококки n Стрептококки
Грамположительные кокки n Стафилококки n Стрептококки
 Стафилококки
Стафилококки
 Таксономия Phylum BXIII. Firmicutes n Class III. "Bacilli" n Order I. Bacillales n Family V. "Staphylococcaceae" n Genus I. Staphylococcus n Species. S. aureus, S. epidermidis, S. saprophyticus n
Таксономия Phylum BXIII. Firmicutes n Class III. "Bacilli" n Order I. Bacillales n Family V. "Staphylococcaceae" n Genus I. Staphylococcus n Species. S. aureus, S. epidermidis, S. saprophyticus n
 Морфология n n n округлые клетки диаметром 0, 5 -1 мкм; «гроздья винограда» плазмиды – синтез коагулазы, гемолитических токсинов, фибринолизина, пигментов, устойчивости к антибиотикам; спор не образуют, жгутиков не имеют; могут образовывать капсулу, чаще полисахаридной природы. могут образовывать L-формы.
Морфология n n n округлые клетки диаметром 0, 5 -1 мкм; «гроздья винограда» плазмиды – синтез коагулазы, гемолитических токсинов, фибринолизина, пигментов, устойчивости к антибиотикам; спор не образуют, жгутиков не имеют; могут образовывать капсулу, чаще полисахаридной природы. могут образовывать L-формы.
 Тинкториальные свойства n Грамположительны
Тинкториальные свойства n Грамположительны
Культуральные свойства n n факультативные анаэробы (хемоорганотрофы с окислительным и бродильным типом метаболизма); хорошо растут на простых средах (р. Н 7, 0): на жидких – помутнение среды с последующим выпадением осадка, при аэрации на поверхности бульона образуется пленка; на плотных – S и R колонии с различным пигментом (золотистым, палевым, лимонно-желтым, белым); могут расти на агаре с высоким содержанием Na. Cl (8 -10%); на кровяном агаре – гемолиз.
Культуральные свойства n n факультативные анаэробы (хемоорганотрофы с окислительным и бродильным типом метаболизма); хорошо растут на простых средах (р. Н 7, 0): на жидких – помутнение среды с последующим выпадением осадка, при аэрации на поверхности бульона образуется пленка; на плотных – S и R колонии с различным пигментом (золотистым, палевым, лимонно-желтым, белым); могут расти на агаре с высоким содержанием Na. Cl (8 -10%); на кровяном агаре – гемолиз.
Рост на кровяном агаре S. aureus и S. epidermidis
Рост на кровяном агаре S. aureus и S. epidermidis
 Ферментативные свойства n n n n биохимически активны: ферментируют с выделением кислоты глицерин, мальтозу, сахарозу, маннит, восстанавливают нитраты в нитриты, продуцируют уреазу, фосфатазу, аргиназу. Глюкозу ферментируют как в аэробных и анаэробных условиях. Выделяют сероводород и аммиак. Оксидазоотрицательны. Стафилококки делятся на каталазоположительные (S. aureus) и каталазоотрицательные (S. epidermidis, S. saprophyticus ). S. epidermidis не сбраживает маннита. S. saprophyticus не сбраживает маннозу, не продуцирует фосфатазу. Глюкоза Лактоза Маннит Сахароза К К H 2 S Индол + –
Ферментативные свойства n n n n биохимически активны: ферментируют с выделением кислоты глицерин, мальтозу, сахарозу, маннит, восстанавливают нитраты в нитриты, продуцируют уреазу, фосфатазу, аргиназу. Глюкозу ферментируют как в аэробных и анаэробных условиях. Выделяют сероводород и аммиак. Оксидазоотрицательны. Стафилококки делятся на каталазоположительные (S. aureus) и каталазоотрицательные (S. epidermidis, S. saprophyticus ). S. epidermidis не сбраживает маннита. S. saprophyticus не сбраживает маннозу, не продуцирует фосфатазу. Глюкоза Лактоза Маннит Сахароза К К H 2 S Индол + –
 Патогенность n n n n адгезия: тейхоевые кислоты, капсульные полисахариды; капсула: индукция цитокинов → возникновение очагов воспаления → образование абсцессов; подавление активности фагоцитов; факторы угнетающие фагоцитоз (белок А, пептидогликан, тейхоевые кислоты); около 30 ферментов агрессии: плазмокоагулаза, ДНКаза, лейкоцидины, лецитовителлаза, фосфатаза, бактериоцины, гемолизины α, β, γ, δ, фибринолизин, и др. каталаза, каратиноидные пигменты – защита от оксидантов; устойчивость к антибиотикам: R-плазмиды, β-лактамазы; токсины.
Патогенность n n n n адгезия: тейхоевые кислоты, капсульные полисахариды; капсула: индукция цитокинов → возникновение очагов воспаления → образование абсцессов; подавление активности фагоцитов; факторы угнетающие фагоцитоз (белок А, пептидогликан, тейхоевые кислоты); около 30 ферментов агрессии: плазмокоагулаза, ДНКаза, лейкоцидины, лецитовителлаза, фосфатаза, бактериоцины, гемолизины α, β, γ, δ, фибринолизин, и др. каталаза, каратиноидные пигменты – защита от оксидантов; устойчивость к антибиотикам: R-плазмиды, β-лактамазы; токсины.
 Токсины стафилококков n n n эксфолиативные токсины А и В – суперантигены, вызывают слущивание эпидермиса, отслойку рогового слоя и развитие синдрома ошпаренной кожи; энтеротоксины А, В, С, С 1 С 2 , D, Е – термостабильные низкомолекулярные белки, суперантигены; токсин синдрома токсического шока (раннее энтеротоксин F) - экзотоксин, характеризующийся слабой гемолитической и высокой протеолитической активностью; β–токсин – цитотоксическое действие; γ–токсин лизирует эритроциты; δ–токсин обладает широким спектром цитотоксической активности.
Токсины стафилококков n n n эксфолиативные токсины А и В – суперантигены, вызывают слущивание эпидермиса, отслойку рогового слоя и развитие синдрома ошпаренной кожи; энтеротоксины А, В, С, С 1 С 2 , D, Е – термостабильные низкомолекулярные белки, суперантигены; токсин синдрома токсического шока (раннее энтеротоксин F) - экзотоксин, характеризующийся слабой гемолитической и высокой протеолитической активностью; β–токсин – цитотоксическое действие; γ–токсин лизирует эритроциты; δ–токсин обладает широким спектром цитотоксической активности.
 Антигенные свойства n n n около 30 АГ: белки, полисахариды и тейхоевые кислоты. выделяют 6 эковаров стафилококков (А, В, С, D, E, F). Эковар А вызывает заболевания у человека, а остальные – у животных. Внутри эковара А выделяют 46 фаговаров. Чувствительность к бактериофагам является стабильной генетической характеристикой, что обусловлено поверхностными рецепторами. Многие штаммы стафилококков являются лизогенными (образование некоторых токсинов происходит с участием профага). В составе клеточной стенки стафилококка содержится протеин А, который может прочно связываться с Fcфрагментом молекулы Ig, (коагглютинация). Большинство внеклеточных веществ, продуцируемых стафилококками, также обладают антигенной активностью.
Антигенные свойства n n n около 30 АГ: белки, полисахариды и тейхоевые кислоты. выделяют 6 эковаров стафилококков (А, В, С, D, E, F). Эковар А вызывает заболевания у человека, а остальные – у животных. Внутри эковара А выделяют 46 фаговаров. Чувствительность к бактериофагам является стабильной генетической характеристикой, что обусловлено поверхностными рецепторами. Многие штаммы стафилококков являются лизогенными (образование некоторых токсинов происходит с участием профага). В составе клеточной стенки стафилококка содержится протеин А, который может прочно связываться с Fcфрагментом молекулы Ig, (коагглютинация). Большинство внеклеточных веществ, продуцируемых стафилококками, также обладают антигенной активностью.
 Патогенез n n n Источник стафилококковой инфекции – человек, животные (больные или носители). 20% людей не поддерживают носительства, 60% – транзиторное носительство, 20% – длительное носительство, (эпидемически опасным считается присутствие более 10 млн. бактерий в 1 мл назального секрета). Механизм передачи – респираторный, контактнобытовой, алиментарный. Восприимчивость людей всеобщая. Входные ворота – кожа, слизистые. Резистентность ↑ – локальная инфекция; ↓ – генерализованная инфекция.
Патогенез n n n Источник стафилококковой инфекции – человек, животные (больные или носители). 20% людей не поддерживают носительства, 60% – транзиторное носительство, 20% – длительное носительство, (эпидемически опасным считается присутствие более 10 млн. бактерий в 1 мл назального секрета). Механизм передачи – респираторный, контактнобытовой, алиментарный. Восприимчивость людей всеобщая. Входные ворота – кожа, слизистые. Резистентность ↑ – локальная инфекция; ↓ – генерализованная инфекция.
 Клиническое разнообразие способность стафилококка вызывать пиогенную инвазию кожи и ее придатков; n проникать в кровь и индуцировать пиогенные (гнойно-деструктивные) поражения внутренних органов; n вызывать неспецифическую (септическую) и специфические интоксикации. n
Клиническое разнообразие способность стафилококка вызывать пиогенную инвазию кожи и ее придатков; n проникать в кровь и индуцировать пиогенные (гнойно-деструктивные) поражения внутренних органов; n вызывать неспецифическую (септическую) и специфические интоксикации. n
 Клиническое разнообразие n n Около 120 клинических форм гнойно-воспалительные болезни кожи и мягких тканей (фурункулы, абсцессы, пиодермии и др. ), поражения глаз, уха, носоглотки, урогенитального тракта, пищеварительной системы (интоксикации), опорнодвигательного аппарата и других органов. Острые кишечные заболевания и менингиты стафилококки вызывают у новорожденных и детей младшего возраста.
Клиническое разнообразие n n Около 120 клинических форм гнойно-воспалительные болезни кожи и мягких тканей (фурункулы, абсцессы, пиодермии и др. ), поражения глаз, уха, носоглотки, урогенитального тракта, пищеварительной системы (интоксикации), опорнодвигательного аппарата и других органов. Острые кишечные заболевания и менингиты стафилококки вызывают у новорожденных и детей младшего возраста.
 Наиболее поражаемые органы. Практически все органы. n Выведение возбудителя во внешнюю среду осуществляется с мокротой, мочой, испражнениями, гнойным отделяемым. n Механизмы саногенеза: гуморальные и клеточные факторы (антитоксины, антимикробные антитела, фагоцитоз). n
Наиболее поражаемые органы. Практически все органы. n Выведение возбудителя во внешнюю среду осуществляется с мокротой, мочой, испражнениями, гнойным отделяемым. n Механизмы саногенеза: гуморальные и клеточные факторы (антитоксины, антимикробные антитела, фагоцитоз). n
 Микробиологическая диагностика Материал: гнойное отделяемое, кровь, спинно-мозговая жидкость, слизь из зева и носа, мокрота, испражнения, моча, рвотные массы, промывные воды желудка, зараженные пищевые продукты. n + ответ ориентировочный. n + основной. Отнесение культуры к роду стафилококков основывается на типичной морфологии и окраске клеток, их взаимном расположении и анаэробной ферментации глюкозы. Для видовой идентификации используют в основном биосинтез плазмокоагулазы, лецитиназы, анаэробную ферментацию маннита и глюкозы. В сомнительных случаях ставят тесты на ДНК-азу и α-токсин. Необходимо использование количественных методов исследования. n – исключение – энтероинфекция, заражают котят. Дермонекротическую пробу проводят на кроликах. n + при хронизации процесса (РНГА, РИФ, ИФА ). n – Тип ответа смешанный – ВТ.
Микробиологическая диагностика Материал: гнойное отделяемое, кровь, спинно-мозговая жидкость, слизь из зева и носа, мокрота, испражнения, моча, рвотные массы, промывные воды желудка, зараженные пищевые продукты. n + ответ ориентировочный. n + основной. Отнесение культуры к роду стафилококков основывается на типичной морфологии и окраске клеток, их взаимном расположении и анаэробной ферментации глюкозы. Для видовой идентификации используют в основном биосинтез плазмокоагулазы, лецитиназы, анаэробную ферментацию маннита и глюкозы. В сомнительных случаях ставят тесты на ДНК-азу и α-токсин. Необходимо использование количественных методов исследования. n – исключение – энтероинфекция, заражают котят. Дермонекротическую пробу проводят на кроликах. n + при хронизации процесса (РНГА, РИФ, ИФА ). n – Тип ответа смешанный – ВТ.
 Лечение и профилактика n n n n антибиотики; антитоксическая стафилококковая плазма или Ig, нормальный донорский Ig; адсорбированный стафилококковый анатоксин; вакцина стафилококковая; бактериофаг стафилококковый. Профилактика стафилококковых инфекций у новорожденных: иммунизация рожениц стафилококковым анатоксином, проведение анализа на обсемененность материнского молока.
Лечение и профилактика n n n n антибиотики; антитоксическая стафилококковая плазма или Ig, нормальный донорский Ig; адсорбированный стафилококковый анатоксин; вакцина стафилококковая; бактериофаг стафилококковый. Профилактика стафилококковых инфекций у новорожденных: иммунизация рожениц стафилококковым анатоксином, проведение анализа на обсемененность материнского молока.
 Стрептококки
Стрептококки
 Таксономия Family VI. Streptococcaceae n Genus I. Streptococcus n Species. S. pyogenes, S. pneumonia, S. agalactia, S. mutans, S. mitis, S. salivarium n
Таксономия Family VI. Streptococcaceae n Genus I. Streptococcus n Species. S. pyogenes, S. pneumonia, S. agalactia, S. mutans, S. mitis, S. salivarium n
 Классификация стрептококков По культуральным признакам. n По гемолитической активности: α-гемолитические – дают частичный гемолиз и зеленоватое окрашивание среды; β-гемолитические – полностью гемолизирующие стрептококки; γ – не гемолитические - не вызывают гемолиз. Альфа и альфа 1 стрептококки называют S. viridans – зеленящие. n Серологическая классификация Ребекки Лэнсфильд (по группоспецифическим полисахаридным АГ клеточной стенки): 20 серологических групп от А до V. Серовары – по специфическим белковым АГ. n
Классификация стрептококков По культуральным признакам. n По гемолитической активности: α-гемолитические – дают частичный гемолиз и зеленоватое окрашивание среды; β-гемолитические – полностью гемолизирующие стрептококки; γ – не гемолитические - не вызывают гемолиз. Альфа и альфа 1 стрептококки называют S. viridans – зеленящие. n Серологическая классификация Ребекки Лэнсфильд (по группоспецифическим полисахаридным АГ клеточной стенки): 20 серологических групп от А до V. Серовары – по специфическим белковым АГ. n
 Стрептококки группы А: S. pyogenes S. pneumonia
Стрептококки группы А: S. pyogenes S. pneumonia
 Streptococcus pyogenes
Streptococcus pyogenes
 Морфология n n n мелкие (0, 5 -2 мкм) шаровидные клетки; располагаются цепочками или попарно; спор не образуют, неподвижны; образуют капсулу, состоящую из гиалуроновой кислоты; клеточная стенка содержит белки (М, - Т- и R), углеводы и пептидогликаны; образуют L-формы.
Морфология n n n мелкие (0, 5 -2 мкм) шаровидные клетки; располагаются цепочками или попарно; спор не образуют, неподвижны; образуют капсулу, состоящую из гиалуроновой кислоты; клеточная стенка содержит белки (М, - Т- и R), углеводы и пептидогликаны; образуют L-формы.
 Тинкториальные свойства n грамположительные
Тинкториальные свойства n грамположительные
 Культуральные свойства n n n Стрептококки – факультативные анаэробы, растут на средах, обогащенных углеводами, кровью, сывороткой, асцитической жидкостью; на плотных питательных средах образуют колонии трех типов: мукоидные – крупные блестящие вязкой консистенции, напоминающие каплю воды (капсульные штаммы), R – штаммы, имеющие М АГ, S – невирулентные штаммы; на жидких средах – придонно-пристеночный рост в виде крошковатого осадка.
Культуральные свойства n n n Стрептококки – факультативные анаэробы, растут на средах, обогащенных углеводами, кровью, сывороткой, асцитической жидкостью; на плотных питательных средах образуют колонии трех типов: мукоидные – крупные блестящие вязкой консистенции, напоминающие каплю воды (капсульные штаммы), R – штаммы, имеющие М АГ, S – невирулентные штаммы; на жидких средах – придонно-пристеночный рост в виде крошковатого осадка.
Культуральные свойства n по характеру роста на кровяном агаре делятся на: α-гемолитические – зеленящие, β-гемолитические, дающие полный гемолиз, негемолитические.
Культуральные свойства n по характеру роста на кровяном агаре делятся на: α-гемолитические – зеленящие, β-гемолитические, дающие полный гемолиз, негемолитические.
 Ферментативные свойства S. pyogenes ферментирует глюкозу, мальтозу, лактозу, сахарозу, маннит с образованием кислоты без газа. n Расщепляет салицин, трегалозу. n Протеолитической активностью не обладает. n
Ферментативные свойства S. pyogenes ферментирует глюкозу, мальтозу, лактозу, сахарозу, маннит с образованием кислоты без газа. n Расщепляет салицин, трегалозу. n Протеолитической активностью не обладает. n
 Антигенные свойства n n Полисахаридный АГ – «субстанция С» (по Ленсфилд) S. pyogenes – серогруппа А. Белковый АГ М – типовой (свыше 100 серотипов серогруппы А). Перекрестные АГ: АТ к ним реагируют с мышечными волокнами миокарда, тканью почки и др. → иммунопатологические состояния. Капсула состоит из гиалуроновой кислоты идентичной обнаруживаемой в соединительной ткани человека (стрептококки не распознаются как «чужие» ).
Антигенные свойства n n Полисахаридный АГ – «субстанция С» (по Ленсфилд) S. pyogenes – серогруппа А. Белковый АГ М – типовой (свыше 100 серотипов серогруппы А). Перекрестные АГ: АТ к ним реагируют с мышечными волокнами миокарда, тканью почки и др. → иммунопатологические состояния. Капсула состоит из гиалуроновой кислоты идентичной обнаруживаемой в соединительной ткани человека (стрептококки не распознаются как «чужие» ).
 Патогенность n n n n Адгезия – капсульные полисахариды, М- (адгезия к кератоцитам и подавление фагоцитоза) и F-белки (адгезия к эпителию респираторного тракта и к клеткам Лангерганса кожи). Инвазия: гиалуронидаза, ДНКаза, РНК-аза, АТФ-аза и др. Стрептокиназа (фибринолизин) – растворение фибрина, генерализация. О-стрептолизин разрушает мембраны клеток, лизосом, кардиотоксичен, АГ – анти-О-стрептолизины. S-стрептолизин – разрушает мембраны. Кардиогепатический токсин вызывает поражения миокарда и диафрагмы, образование гигантоклеточных гранулем в печени. Эритрогенины (термостабильный токсин А, токсин С) – нарушают межклеточные контакты, пирогенность, действуют иммуноопосредовано вызывая образование ярко-красных кожных высыпаний.
Патогенность n n n n Адгезия – капсульные полисахариды, М- (адгезия к кератоцитам и подавление фагоцитоза) и F-белки (адгезия к эпителию респираторного тракта и к клеткам Лангерганса кожи). Инвазия: гиалуронидаза, ДНКаза, РНК-аза, АТФ-аза и др. Стрептокиназа (фибринолизин) – растворение фибрина, генерализация. О-стрептолизин разрушает мембраны клеток, лизосом, кардиотоксичен, АГ – анти-О-стрептолизины. S-стрептолизин – разрушает мембраны. Кардиогепатический токсин вызывает поражения миокарда и диафрагмы, образование гигантоклеточных гранулем в печени. Эритрогенины (термостабильный токсин А, токсин С) – нарушают межклеточные контакты, пирогенность, действуют иммуноопосредовано вызывая образование ярко-красных кожных высыпаний.
 n n n Патогенез Источник инфекции – больной, реконвалесцент, носитель. Механизмы передачи – аспирационный, контактный, реже алиментарный. Пути передачи – воздушно-капельный, прямой и непрямой контакт, пищевой. Входные ворота – миндалины, слизистые оболочки верхних дыхательных путей, поврежденная кожа, у новорожденных – пупочная ранка. ↑ резистентность –локальная инфекция, ↓ резистентность –генерализация (лимфо- и гематогенно). Наиболее поражаемый орган – небные миндалины (тонзилит), сердечная мышца, кожа, подкожная клетчатка (рожа, скарлатина); почка (острый гломерулонефрит).
n n n Патогенез Источник инфекции – больной, реконвалесцент, носитель. Механизмы передачи – аспирационный, контактный, реже алиментарный. Пути передачи – воздушно-капельный, прямой и непрямой контакт, пищевой. Входные ворота – миндалины, слизистые оболочки верхних дыхательных путей, поврежденная кожа, у новорожденных – пупочная ранка. ↑ резистентность –локальная инфекция, ↓ резистентность –генерализация (лимфо- и гематогенно). Наиболее поражаемый орган – небные миндалины (тонзилит), сердечная мышца, кожа, подкожная клетчатка (рожа, скарлатина); почка (острый гломерулонефрит).
 Клиническое многообразие n n S. pyogenes может вызывать у человека: гнойно-воспалительные процессы (ангина, абсцессы, флегмоны, гаймориты, фронтиты, лимфадениты, циститы, пиелонефриты и др. ), ненагноительные воспалительные процессы (рожа, стрептодермия, импетиго, скарлатина, острая ревматическая инфекция гломерулонефрит, эндокардит и др. ), генерализованные формы инфекции – токсический шок, сепсис.
Клиническое многообразие n n S. pyogenes может вызывать у человека: гнойно-воспалительные процессы (ангина, абсцессы, флегмоны, гаймориты, фронтиты, лимфадениты, циститы, пиелонефриты и др. ), ненагноительные воспалительные процессы (рожа, стрептодермия, импетиго, скарлатина, острая ревматическая инфекция гломерулонефрит, эндокардит и др. ), генерализованные формы инфекции – токсический шок, сепсис.
 Скарлатина n n n Острое инфекционное заболевание, характеризующееся ангиной, общей интоксикацией, появлением точечных высыпаний на шее и груди ярко-красного цвета (scarlatinum – красный цвет). Скарлатинозный синдром – эритрогенный токсин. Болеют дети от 1 года до 8 лет.
Скарлатина n n n Острое инфекционное заболевание, характеризующееся ангиной, общей интоксикацией, появлением точечных высыпаний на шее и груди ярко-красного цвета (scarlatinum – красный цвет). Скарлатинозный синдром – эритрогенный токсин. Болеют дети от 1 года до 8 лет.
 Рожа n n n Острое флегмоноподобное воспаление кожи. erysipelas (греч. – красная кожа). Инфекция распространяется в субэпителиальной ткани лица, головы, нижних конечностей, реже других частей тела.
Рожа n n n Острое флегмоноподобное воспаление кожи. erysipelas (греч. – красная кожа). Инфекция распространяется в субэпителиальной ткани лица, головы, нижних конечностей, реже других частей тела.
 Ревматизм, гломерулонефрит n n n Механизмы патогенеза: перекрестные АГ стрептококка, развитие гиперчувствительности иммунокомплексного типа, длительная персистенция L-форм стрептококков. ревматизму чаще предшествуют поражение миндалин и глотки; гломерулонефриту – кожные формы стрептококковой инфекции.
Ревматизм, гломерулонефрит n n n Механизмы патогенеза: перекрестные АГ стрептококка, развитие гиперчувствительности иммунокомплексного типа, длительная персистенция L-форм стрептококков. ревматизму чаще предшествуют поражение миндалин и глотки; гломерулонефриту – кожные формы стрептококковой инфекции.
 Механизмы саногенеза Антитоксины, типоспецифические Мантитела, иммунный фагоцитоз. n После перенесения скарлатины формируется напряженный антитоксический иммунитет. n
Механизмы саногенеза Антитоксины, типоспецифические Мантитела, иммунный фагоцитоз. n После перенесения скарлатины формируется напряженный антитоксический иммунитет. n
 Микробиологическая диагностика Материал : гной, слизь из зева и носа, моча и др. При подозрении на сепсис – кровь. 1. + ориентировочный. 2. + основной. Материал засевают на кровяной агар, колонии характеризуют по характеру гемолиза, идентифицируют по антигенным свойствам в РП со специфическими сыворотками. Для дифференциации стрептококков группы А от других βгемолитических стрептококков применяют тест чувствительности к бацитрацину (чувствительны). РИФ, ИФА, ПЦР.
Микробиологическая диагностика Материал : гной, слизь из зева и носа, моча и др. При подозрении на сепсис – кровь. 1. + ориентировочный. 2. + основной. Материал засевают на кровяной агар, колонии характеризуют по характеру гемолиза, идентифицируют по антигенным свойствам в РП со специфическими сыворотками. Для дифференциации стрептококков группы А от других βгемолитических стрептококков применяют тест чувствительности к бацитрацину (чувствительны). РИФ, ИФА, ПЦР.
 Микробиологическая диагностика 3. +Вирулентность микроорганизмов определяют внутрибрюшинным введением культуры стрептококков кроликам. 4. + при хронических формах, для подтверждения диагноза ревматизма. АТ к О-стрептолизину в РСК или РП. 5. – тип иммунного ответа ВТ.
Микробиологическая диагностика 3. +Вирулентность микроорганизмов определяют внутрибрюшинным введением культуры стрептококков кроликам. 4. + при хронических формах, для подтверждения диагноза ревматизма. АТ к О-стрептолизину в РСК или РП. 5. – тип иммунного ответа ВТ.
 Лечение и профилактика Лечение антибиотиками ( -лактамы, макролиды). n Стрептококковый бактериофаг. n При скарлатине ослабленным детям вводят иммуноглобулин. n Профилактика неспецифическая. n
Лечение и профилактика Лечение антибиотиками ( -лактамы, макролиды). n Стрептококковый бактериофаг. n При скарлатине ослабленным детям вводят иммуноглобулин. n Профилактика неспецифическая. n
 Пневмококки Streptococcus pneumoniae n Может вызывать пневмонии, бронхиты, воспалительные процессы ВДП и пазух носа, среднего уха, роговицы, сепсис, менингит, эндокардит, артрит и т. д.
Пневмококки Streptococcus pneumoniae n Может вызывать пневмонии, бронхиты, воспалительные процессы ВДП и пазух носа, среднего уха, роговицы, сепсис, менингит, эндокардит, артрит и т. д.
 Морфология n n ланцетовидные диплококки, короткие цепочки; полисахаридная капсула; М-протеин иной антигенной специфичности, чем у S. pyogenes; неподвижны, спор не образуют.
Морфология n n ланцетовидные диплококки, короткие цепочки; полисахаридная капсула; М-протеин иной антигенной специфичности, чем у S. pyogenes; неподвижны, спор не образуют.
 Тинкториальные свойства n Грамположительны
Тинкториальные свойства n Грамположительны
 Культивирование n n n факультативные анаэробы; на питательных средах теряют капсулу и переходят из S- в R-форму; растут на кровяных и сывороточных средах; на кровяном агаре образуют мелкие, точечные колонии, окруженные неполной зоной гемолиза ( -гемолиз); рост на питательных средах угнетается оптохином.
Культивирование n n n факультативные анаэробы; на питательных средах теряют капсулу и переходят из S- в R-форму; растут на кровяных и сывороточных средах; на кровяном агаре образуют мелкие, точечные колонии, окруженные неполной зоной гемолиза ( -гемолиз); рост на питательных средах угнетается оптохином.
 Ферментативные свойства Расщепляют до кислоты, без газа глюкозу, мальтозу, галактозу и др. n Оксидазу и каталазу не продуцирует. n
Ферментативные свойства Расщепляют до кислоты, без газа глюкозу, мальтозу, галактозу и др. n Оксидазу и каталазу не продуцирует. n
 Антигенная структура S. pneumoniae содержит: поверхностный полисахаридный капсульный АГ; полисахаридный АГ клеточной стенки (С-полисахарид) – видоспецифический АГ; М-протеин. n По капсульному АГ – 90 сероваров. n
Антигенная структура S. pneumoniae содержит: поверхностный полисахаридный капсульный АГ; полисахаридный АГ клеточной стенки (С-полисахарид) – видоспецифический АГ; М-протеин. n По капсульному АГ – 90 сероваров. n
 Патогенность n n n n Адгезия – капсульные полисахариды, тейхоевые кислоты и М-белок; нейраминидаза; Цитотоксин (пневмолизин); гемолизины; ферменты: пептидаза, расщепляющая Ig. A, гиалуронидаза, способствующая распространению пневмококка в тканях; агрессины, подавляющие фагоцитоз (капсула, протеин М); мурамидаза (лизоцим), подавляющая многие бактерии → колонизация.
Патогенность n n n n Адгезия – капсульные полисахариды, тейхоевые кислоты и М-белок; нейраминидаза; Цитотоксин (пневмолизин); гемолизины; ферменты: пептидаза, расщепляющая Ig. A, гиалуронидаза, способствующая распространению пневмококка в тканях; агрессины, подавляющие фагоцитоз (капсула, протеин М); мурамидаза (лизоцим), подавляющая многие бактерии → колонизация.
 Патогенез n n n Источник – больной, носитель. Механизмы заражения – аспирационный, контактный. Путь – воздушно-капельный, прямой контакт. Входные ворота – слизистые ВДП. Инфицирование слизистых респираторного тракта чаще происходит при нарушении их целостности вирусами (риновирусы, аденовирусы). Пневмококки вызывают бронхиты, пневмонию, реже бактериемию, септицемию и менингит. Генерализованные формы чаще встречаются у маленьких детей и пожилых людей.
Патогенез n n n Источник – больной, носитель. Механизмы заражения – аспирационный, контактный. Путь – воздушно-капельный, прямой контакт. Входные ворота – слизистые ВДП. Инфицирование слизистых респираторного тракта чаще происходит при нарушении их целостности вирусами (риновирусы, аденовирусы). Пневмококки вызывают бронхиты, пневмонию, реже бактериемию, септицемию и менингит. Генерализованные формы чаще встречаются у маленьких детей и пожилых людей.
 Иммунитет к пневмококковой инфекции типоспецифический. n Реализуется через АТ, фагоцитоз и комплемента. n
Иммунитет к пневмококковой инфекции типоспецифический. n Реализуется через АТ, фагоцитоз и комплемента. n
 Микробиологическая диагностика Материал: мокрота, смывы с бронхов, плевральная жидкость. 1. + ориентировочный. 2. + основной. Количественный: 106 3. + биопроба с целью выделения чистой культуры. 4. + РНИФ, ИФА. 5. –.
Микробиологическая диагностика Материал: мокрота, смывы с бронхов, плевральная жидкость. 1. + ориентировочный. 2. + основной. Количественный: 106 3. + биопроба с целью выделения чистой культуры. 4. + РНИФ, ИФА. 5. –.
 Лечение и профилактика Для лечения – антибиотики (β-лактамы, макролиды и др. ). n Пневмококки чувствительны ко многим антибактериальным препаратам, включая пенициллины. n Вакцина разработана, но ее эффективность и целесообразность применения не бесспорны. n
Лечение и профилактика Для лечения – антибиотики (β-лактамы, макролиды и др. ). n Пневмококки чувствительны ко многим антибактериальным препаратам, включая пенициллины. n Вакцина разработана, но ее эффективность и целесообразность применения не бесспорны. n
 Стрептококки группы В n n n S. agalactia – β-гемолитический стрептококк. Отличие от S. pyogenes: группоспецифический АГ. S. agalactia колонизирует слизистую оболочку влагалища, выделяется от 10% здоровых женщин, а при беременности – до 25%. S. agalactia наиболее опасен для новорожденных (заражаются проходя через инфицированный родовой канал). Может вызывать послеродовые и урогенитальные инфекции, маститы и вагиниты у женщин, сепсис и менингиты у новорожденных.
Стрептококки группы В n n n S. agalactia – β-гемолитический стрептококк. Отличие от S. pyogenes: группоспецифический АГ. S. agalactia колонизирует слизистую оболочку влагалища, выделяется от 10% здоровых женщин, а при беременности – до 25%. S. agalactia наиболее опасен для новорожденных (заражаются проходя через инфицированный родовой канал). Может вызывать послеродовые и урогенитальные инфекции, маститы и вагиниты у женщин, сепсис и менингиты у новорожденных.
 Зеленящие стрептококки группы viridans, лишенные группоспецифического антигена n n Группа оральных стрептококков (S. mutans, S. salivarium, S. sanguis, S. oralis и др. ). Отличаются от S. pyogenes образованием мембранотоксина с -гемолитической активностью. Продуцируют полисахаридный адгезин, способствующий прилипанию бактерий к сердечным клапанам и зубам. Могут вызывать стоматологические заболевания, бактериемию, септический эндокардит.
Зеленящие стрептококки группы viridans, лишенные группоспецифического антигена n n Группа оральных стрептококков (S. mutans, S. salivarium, S. sanguis, S. oralis и др. ). Отличаются от S. pyogenes образованием мембранотоксина с -гемолитической активностью. Продуцируют полисахаридный адгезин, способствующий прилипанию бактерий к сердечным клапанам и зубам. Могут вызывать стоматологические заболевания, бактериемию, септический эндокардит.
 Энтерококки n n n Family Enterococcaceae E. faecalis – 80 -90%, E. faecium – 10 -15% E. faecalis – условно-патогенный микроорганизм, имеющий санитарно-показательное значение, является обитателем кишечника человека. Вызывает раневую инфекцию, гнойновоспалительные заболевания желчно-выводящих путей, эндокардиты, перитониты, уроинфекции (чаще всего в ассоциациях с кишечной палочкой, протеем, золотистым стафилококком). E. faecalis может размножаться в пищевых продуктах и вызывает пищевые токсикоинфекции. Устойчив к антибиотикам.
Энтерококки n n n Family Enterococcaceae E. faecalis – 80 -90%, E. faecium – 10 -15% E. faecalis – условно-патогенный микроорганизм, имеющий санитарно-показательное значение, является обитателем кишечника человека. Вызывает раневую инфекцию, гнойновоспалительные заболевания желчно-выводящих путей, эндокардиты, перитониты, уроинфекции (чаще всего в ассоциациях с кишечной палочкой, протеем, золотистым стафилококком). E. faecalis может размножаться в пищевых продуктах и вызывает пищевые токсикоинфекции. Устойчив к антибиотикам.
 Грамотрицательные кокки Основное значение – Neisseria (N. meningitidis и N. gonorrhoeae). n Представители родов Bronhamella, Moraxella могут вызывать у человека воспалительные процессы. n Acinetobacter – внутрибольничные инфекции. n
Грамотрицательные кокки Основное значение – Neisseria (N. meningitidis и N. gonorrhoeae). n Представители родов Bronhamella, Moraxella могут вызывать у человека воспалительные процессы. n Acinetobacter – внутрибольничные инфекции. n
 Нейссерии
Нейссерии
 Таксономия Family. Neisseriaceae n Genus. Neisseria n Species. N. meningitidis, N. gonorrhoeae n
Таксономия Family. Neisseriaceae n Genus. Neisseria n Species. N. meningitidis, N. gonorrhoeae n
 Менингококки Neisseria meningitidis n Менингококковая инфекция – острая инфекционная болезнь, характеризующаяся поражением слизистой оболочки носоглотки, оболочек головного мозга и септицемией; антропоноз.
Менингококки Neisseria meningitidis n Менингококковая инфекция – острая инфекционная болезнь, характеризующаяся поражением слизистой оболочки носоглотки, оболочек головного мозга и септицемией; антропоноз.
 Морфология n n n Мелкие (0, 6 -0, 8 мкм) диплококки. Пара бобовидных клеток, обращенных вогнутыми поверхностями друг к другу (кофейные зерна). Неподвижны, спор не образуют, грамотрицательны, имеют пили, капсула непостоянна.
Морфология n n n Мелкие (0, 6 -0, 8 мкм) диплококки. Пара бобовидных клеток, обращенных вогнутыми поверхностями друг к другу (кофейные зерна). Неподвижны, спор не образуют, грамотрицательны, имеют пили, капсула непостоянна.
Культивирование n n Менингококки – аэробы, обладают цитохромоксидазой и каталазой. Растут на средах с сывороткой или кровью барана, лошади, содержащих специальный набор аминокислот, ристомицин. Повышенная концентрация СО 2 в атмосфере стимулирует рост менингококков. На сывороточном агаре образуют бесцветные нежные колонии вязкой консистенции.
Культивирование n n Менингококки – аэробы, обладают цитохромоксидазой и каталазой. Растут на средах с сывороткой или кровью барана, лошади, содержащих специальный набор аминокислот, ристомицин. Повышенная концентрация СО 2 в атмосфере стимулирует рост менингококков. На сывороточном агаре образуют бесцветные нежные колонии вязкой консистенции.
 Ферментативные свойства n Менингококки расщепляют с образованием кислоты глюкозу и мальтозу.
Ферментативные свойства n Менингококки расщепляют с образованием кислоты глюкозу и мальтозу.
 Антигенная структура n n n По капсульным АГ – серогруппы А, В, С, D и др. По АГ клеточной стенки – серовары (1, 2, 3 и т. д. ). Во время эпидемических вспышек обычно циркулируют менингококки группы А, они же чаще встречаются при генерализованных формах инфекции. В настоящее время чаще выделяются менингококки серогрупп В и С.
Антигенная структура n n n По капсульным АГ – серогруппы А, В, С, D и др. По АГ клеточной стенки – серовары (1, 2, 3 и т. д. ). Во время эпидемических вспышек обычно циркулируют менингококки группы А, они же чаще встречаются при генерализованных формах инфекции. В настоящее время чаще выделяются менингококки серогрупп В и С.
 Патогенность n n Пили, белки наружной мембраны – адгезия; капсульные полисахариды –резистентность к фагоцитозу; нейраминидаза и гиалуронидаза – инвазия в ткани; эндотоксин – ЛПС клеточной стенки, генерализация инфекции, эндотоксический шок.
Патогенность n n Пили, белки наружной мембраны – адгезия; капсульные полисахариды –резистентность к фагоцитозу; нейраминидаза и гиалуронидаза – инвазия в ткани; эндотоксин – ЛПС клеточной стенки, генерализация инфекции, эндотоксический шок.
 Патогенез n n n Источник инфекции – больной или носитель (15 -20% здоровых носителей). Механизм передачи – аспирационный, путь – воздушно-капельный. Встречается преимущественно в зимне-весенний период. Входные ворота – слизистые ВДП. Динамика распространения: локальная (назофарингит), генерализованная с прорывом гематоэнцефалического барьера. Гематогенная диссеминация. Наиболее поражаемые органы – оболочки мозга, мозг (головной, спинной – менингит, менингоэнцефалит), легкие (пневмонии).
Патогенез n n n Источник инфекции – больной или носитель (15 -20% здоровых носителей). Механизм передачи – аспирационный, путь – воздушно-капельный. Встречается преимущественно в зимне-весенний период. Входные ворота – слизистые ВДП. Динамика распространения: локальная (назофарингит), генерализованная с прорывом гематоэнцефалического барьера. Гематогенная диссеминация. Наиболее поражаемые органы – оболочки мозга, мозг (головной, спинной – менингит, менингоэнцефалит), легкие (пневмонии).
 Патогенез n n n Ведущая роль в патогенезе тяжелых форм – инфекционно-токсический шок. Причины смерти: острая сердечно-сосудистая недостаточность, отек головного мозга и легких, острая почечная недостаточность. Летальность при менингококковой инфекции достигает 12, 5%.
Патогенез n n n Ведущая роль в патогенезе тяжелых форм – инфекционно-токсический шок. Причины смерти: острая сердечно-сосудистая недостаточность, отек головного мозга и легких, острая почечная недостаточность. Летальность при менингококковой инфекции достигает 12, 5%.
 Иммунитет n n n Постинфекционный иммунитет при генерализованных формах инфекции стойкий, напряженный. АТ к различным АГ клетки (полисахаридам и белкам). Полисахаридные АГ сероваров А и С обладают высокой иммуногенностью, полисахариды сероваров В почти неимуногенны. АТ от иммунизированной матери могут передаваться плоду трансплацентарным путем и обнаруживаются в течение 2 -5 мес. после рождения ребенка.
Иммунитет n n n Постинфекционный иммунитет при генерализованных формах инфекции стойкий, напряженный. АТ к различным АГ клетки (полисахаридам и белкам). Полисахаридные АГ сероваров А и С обладают высокой иммуногенностью, полисахариды сероваров В почти неимуногенны. АТ от иммунизированной матери могут передаваться плоду трансплацентарным путем и обнаруживаются в течение 2 -5 мес. после рождения ребенка.
 Микробиологическая диагностика Материал: кровь, СМЖ, носоглоточные смывы. 1. + микроскопия осадка центрифугированной СМЖ и мазков из зева; при менингококцемии – микроскопия толстой капли крови.
Микробиологическая диагностика Материал: кровь, СМЖ, носоглоточные смывы. 1. + микроскопия осадка центрифугированной СМЖ и мазков из зева; при менингококцемии – микроскопия толстой капли крови.
 Микробиологическая диагностика 2. 3. 4. 5. + Посев на шоколадный агар, на агар с ристомицином (или линкомицином), на среду Мартена – агар с антибиотиками (ВКН – ванкомицин, колистин, нистатин). Идентификация: морфология, Г «–» , оксидаза+, серовар. Экспресс-диагностика: определение АГ в СМЖ и ПЦР. – + РНГА, ИФА. – Ответ ВТ.
Микробиологическая диагностика 2. 3. 4. 5. + Посев на шоколадный агар, на агар с ристомицином (или линкомицином), на среду Мартена – агар с антибиотиками (ВКН – ванкомицин, колистин, нистатин). Идентификация: морфология, Г «–» , оксидаза+, серовар. Экспресс-диагностика: определение АГ в СМЖ и ПЦР. – + РНГА, ИФА. – Ответ ВТ.
 Лечение и профилактика n n n Антибиотики (пенициллины, левомицетин, рифампицин). Специфическая профилактика: менингококковая химическая полисахаридная вакцина по эпидемическим показаниям при эпидемическом подъеме заболеваемости, в очагах менингококковой инфекции, в группах населения повышенного риска (дети старше 5 лет в организованных коллективах, студенты первых курсов средних и высших учебных заведений, заключенные и др. ). Иммуноглобулин человека нормальный вводят детям в возрасте от 6 мес до 7 лет не позднее 7 суток после контакта с больным генерализованной формой менингококковой инфекции.
Лечение и профилактика n n n Антибиотики (пенициллины, левомицетин, рифампицин). Специфическая профилактика: менингококковая химическая полисахаридная вакцина по эпидемическим показаниям при эпидемическом подъеме заболеваемости, в очагах менингококковой инфекции, в группах населения повышенного риска (дети старше 5 лет в организованных коллективах, студенты первых курсов средних и высших учебных заведений, заключенные и др. ). Иммуноглобулин человека нормальный вводят детям в возрасте от 6 мес до 7 лет не позднее 7 суток после контакта с больным генерализованной формой менингококковой инфекции.
 Возбудитель гонореи Neisseria gonorrhoeae n Гонорея – инфекционная венерическая болезнь, вызываемая гонококками, характеризуется гнойным воспалением слизистых оболочек, чаще мочеполовой системы.
Возбудитель гонореи Neisseria gonorrhoeae n Гонорея – инфекционная венерическая болезнь, вызываемая гонококками, характеризуется гнойным воспалением слизистых оболочек, чаще мочеполовой системы.
 Морфология n Гонококк – Г «–» диплококк бобовидной формы, неподвижен; спор не образует, в организме образует нежную капсулу, имеет пили.
Морфология n Гонококк – Г «–» диплококк бобовидной формы, неподвижен; спор не образует, в организме образует нежную капсулу, имеет пили.
 Культивирование n n Гонококк – аэроб, требователен к питательным средам. Применяют сывороточный, асцитический, кровяной или шоколадный агары. На асцит-агаре образуют прозрачные колонии с ровными краями. Оптимальные условия для культивирования: 370 С, повышенная концентрация СО 2 (5 -10%) в атмосфере.
Культивирование n n Гонококк – аэроб, требователен к питательным средам. Применяют сывороточный, асцитический, кровяной или шоколадный агары. На асцит-агаре образуют прозрачные колонии с ровными краями. Оптимальные условия для культивирования: 370 С, повышенная концентрация СО 2 (5 -10%) в атмосфере.
 Ферментативные свойства n Ферментирует только глюкозу, образует каталазу и цитохромоксидазу.
Ферментативные свойства n Ферментирует только глюкозу, образует каталазу и цитохромоксидазу.
 Патогенность n n n Пили: адгезия, передвижение по слизистой, образование биопленки. Эндотоксин – ЛПС клеточной стенки. Капсулярные полисахариды подавляют фагоцитоз. Характерной особенностью гонококков является их способность проникать в лейкоциты и размножаться в них.
Патогенность n n n Пили: адгезия, передвижение по слизистой, образование биопленки. Эндотоксин – ЛПС клеточной стенки. Капсулярные полисахариды подавляют фагоцитоз. Характерной особенностью гонококков является их способность проникать в лейкоциты и размножаться в них.
 Патогенез n n n n Источник инфекции – больной человек. Механизм передачи – контактный, пути – половой (гонорея) и прямой контакт (бленорея). Редко – непрямой контакт (постельное белье, полотенце, мочалка). Входные ворота – слизистая половых органов, прямой кишки, зева, конъюнктива глаза. Чаще – локальная инфекция (уретрит, цервицит, поражение шейки матки, придатков у мужчин семенных пузырьков, престательной железы; при экстрагенитальной локализации – повреждение прямой кишки, миндалин, бленорея новорожденных), у лиц со сниженной резистентностью – генерализация процесса (артрит, эндокардит, менингит). Наиболее поражаемые органы – слизистая, подслизистая мочеполовых путей, конъюнктива, селезенка, костный мозг, печень, суставы (при генерализации). Бессимптомное течение (у женщин – в 60 -80%). Пути выведения – гнойное отделяемое.
Патогенез n n n n Источник инфекции – больной человек. Механизм передачи – контактный, пути – половой (гонорея) и прямой контакт (бленорея). Редко – непрямой контакт (постельное белье, полотенце, мочалка). Входные ворота – слизистая половых органов, прямой кишки, зева, конъюнктива глаза. Чаще – локальная инфекция (уретрит, цервицит, поражение шейки матки, придатков у мужчин семенных пузырьков, престательной железы; при экстрагенитальной локализации – повреждение прямой кишки, миндалин, бленорея новорожденных), у лиц со сниженной резистентностью – генерализация процесса (артрит, эндокардит, менингит). Наиболее поражаемые органы – слизистая, подслизистая мочеполовых путей, конъюнктива, селезенка, костный мозг, печень, суставы (при генерализации). Бессимптомное течение (у женщин – в 60 -80%). Пути выведения – гнойное отделяемое.
 Иммунитет n n Иммунитет не формируется (высокая изменчивость, низкая иммуногенность ЛПС). Организм борется за счет опсонофагоцитарной реакции и бактерицидной системы сыворотки крови. В крови появляются АТ, но они не обладают протективными свойствами. Ig. A подавляют прикрепление пилей возбудителя к клеткам слизистой уретры, но не могут защитить слизистую от последующего заражения новыми генерациями гонококков с измененной антигенной структурой → реинфекция, рецидивы, хронизация.
Иммунитет n n Иммунитет не формируется (высокая изменчивость, низкая иммуногенность ЛПС). Организм борется за счет опсонофагоцитарной реакции и бактерицидной системы сыворотки крови. В крови появляются АТ, но они не обладают протективными свойствами. Ig. A подавляют прикрепление пилей возбудителя к клеткам слизистой уретры, но не могут защитить слизистую от последующего заражения новыми генерациями гонококков с измененной антигенной структурой → реинфекция, рецидивы, хронизация.
 Микробиологическая диагностика 1. 2. 3. 4. 5. + основной: бактериоскопия препаратов гнойного отделяемого, окрашенного по Граму или метиленовым синим. + при отсутствии результатов микроскопии, особенно при женской гонореи. РИФ и ПЦР. – + при хронической форме. – ВТ-ответ.
Микробиологическая диагностика 1. 2. 3. 4. 5. + основной: бактериоскопия препаратов гнойного отделяемого, окрашенного по Граму или метиленовым синим. + при отсутствии результатов микроскопии, особенно при женской гонореи. РИФ и ПЦР. – + при хронической форме. – ВТ-ответ.
 Лечение и профилактика n n Лечение – антибиотикотерапия (β-лактамы: цефтриаксон, ципрофлоксацин). Специфическая профилактика не разработана. Экстренная профилактика: местное применение 0, 05% раствора биглюконата хлоргексидина; мерой предупреждения инфицирования является использование презерватива. Для предупреждения бленореи всем новорожденным на конъюнктиву глаза закапывают раствор антибиотика. Вакцина гонококковая предназначен для диагностики (установлении излеченности) гонореи и в качестве вспомогательного метода лечения гонорейной инфекции наряду с другими средствами терапии (больным после безуспешной антибиотикотерапии, при вяло протекающих рецидивах, при хронических формах, мужчинам с осложненной и женщинам с восходящей гонореей, в гинекологической практике при лечении воспалительных процессов).
Лечение и профилактика n n Лечение – антибиотикотерапия (β-лактамы: цефтриаксон, ципрофлоксацин). Специфическая профилактика не разработана. Экстренная профилактика: местное применение 0, 05% раствора биглюконата хлоргексидина; мерой предупреждения инфицирования является использование презерватива. Для предупреждения бленореи всем новорожденным на конъюнктиву глаза закапывают раствор антибиотика. Вакцина гонококковая предназначен для диагностики (установлении излеченности) гонореи и в качестве вспомогательного метода лечения гонорейной инфекции наряду с другими средствами терапии (больным после безуспешной антибиотикотерапии, при вяло протекающих рецидивах, при хронических формах, мужчинам с осложненной и женщинам с восходящей гонореей, в гинекологической практике при лечении воспалительных процессов).


